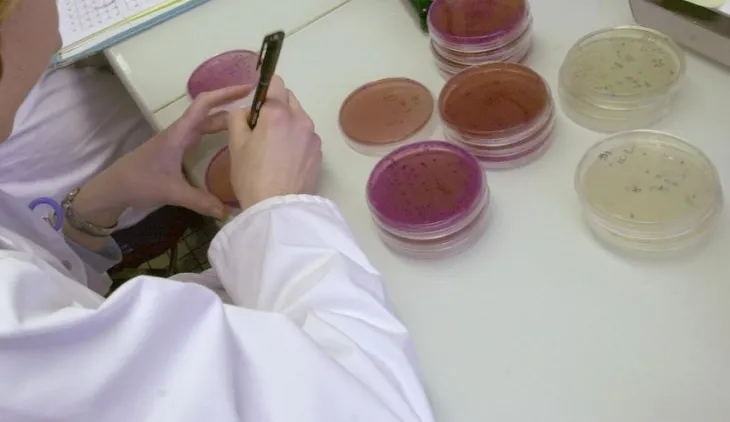
Nuevo Siglo

En Colombia, el 35% de las personas viven en zonas de amenaza sísmica alta y el 20 % en zonas con algún grado de amenaza volcánica.
Esos patógenos podrían matar a hasta 10 millones de personas al año de aquí a 2050, según un informe.
Tras las heladas se constató que sobre cipreses y eucaliptos estaban agrupadas formando racimos alargados de color gris con manchas anaranjadas
OpenAI lanzó a finales del año pasado una versión gratuita de su chat robotizado ChatGPT capaz de responder preguntas
En el departamento hay 80 municipios con alta probabilidad de incendio, 25 están alerta roja y 50 en alerta naranja.
Natura realizó la primera exportación a Brasil de manteca de copoazú cultivada en la Amazonía colombiana
El nuevo espécimen se caracteriza por su silencio, la rana de carrizo de garganta espinosa de Ukaguru no croa, no canta y no gorjea
Wolf 1069 tiene una masa aproximada a la dela Tierra y su superficie es relativamente fría.
El secretario de la Comisión Económica para América Latina y el Caribe instó a las naciones unir esfuerzos en pro del agua.
Recuperaron 1 loro real amarillo, 4 pericos bronceados, 3 pericos cari-sucios, 2 canarios costeños, 2 aves, 6 Tortugas y 1 Coral de mar.
Investigadores de la Universidad de Hokkaido han hallado indicios de un aumento de las emisiones.
Algunas partes de algunas huellas se parecen a los hilos rizados y en otras parece que el camino serpentea por sí mismo